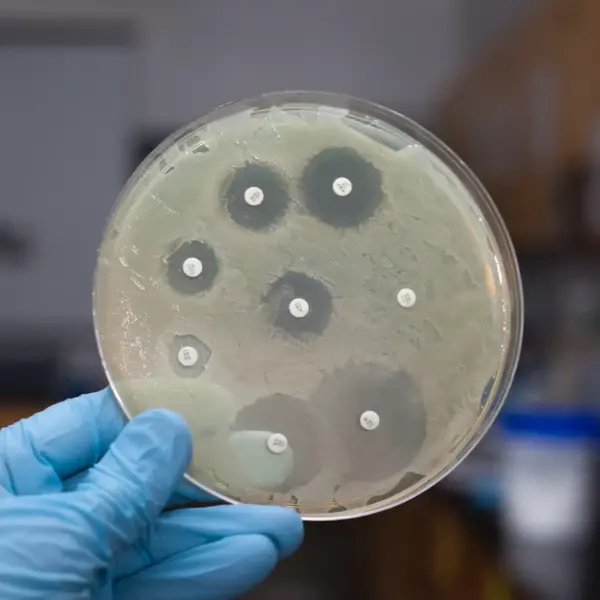
hsm exclusive pool entkeimung 06 24

Willkommen bei HSM Exclusive, Ihrem vertrauenswürdigen Partner für Home Services, Handwerker Services, Pool Services und Garten Services auf der wunderschönen Insel Mallorca. Heute möchten wir über ein Thema sprechen, das für viele Poolbesitzer von entscheidender Bedeutung ist: die Entkeimung des Poolwassers und die zahlreichen Vorteile, die Salzwasser-Pools bieten. Außerdem zeigen wir Ihnen, wie einfach es ist, von einem Süßwasser- auf einen Salzwasser-Pool umzustellen.
Warum ist die Entkeimung von Poolwasser so wichtig?
Die Entkeimung von Poolwasser ist unerlässlich, um die Gesundheit und Sicherheit aller Schwimmer zu gewährleisten. Ohne eine angemessene Desinfektion können sich Bakterien, Viren und Algen im Wasser vermehren, was zu unangenehmen und potenziell gefährlichen Bedingungen führt. Traditionell wird zur Entkeimung von Poolwasser Chlor verwendet, doch immer mehr Poolbesitzer entdecken die Vorteile von Salzwasser-Pools.
Die Vorteile von Salzwasser-Pools
- Angenehmer für die Haut und Augen
Salzwasser-Pools verwenden ein Salzwasserelektrolysesystem, um das Wasser zu desinfizieren. Dies bedeutet, dass weniger Chlor verwendet wird, was das Wasser sanfter für die Haut und Augen macht. Viele Menschen, die auf Chlor empfindlich reagieren, finden Salzwasser-Pools angenehmer und weniger reizend. - Weniger Wartung und geringere Kosten
Ein weiterer großer Vorteil von Salzwasser-Pools ist die geringere Wartung. Während herkömmliche Pools regelmäßige Zugaben von Chlor benötigen, erzeugt ein Salzwassersystem kontinuierlich Chlor aus dem im Wasser gelösten Salz. Dies führt zu einer gleichmäßigen und stabilen Desinfektion, die weniger Pflege und weniger Ausgaben für Chemikalien erfordert. - Uweltfreundlicher
Da Salzwasser-Pools weniger Chlor benötigen, sind sie umweltfreundlicher. Der reduzierte Chemikalienverbrauch bedeutet weniger Umweltbelastung und ein nachhaltigerer Umgang mit Ressourcen. - Bessere Wasserqualität
Salzwasser-Pools bieten eine hervorragende Wasserqualität, die klar und frisch bleibt. Die konstante Produktion von Chlor durch die Elektrolyse sorgt dafür, dass das Wasser stets sauber und sicher ist.
Umstellung von Süßwasser- auf Salzwasser-Pool: So einfach geht’s
Die Umstellung von einem Süßwasser- auf einen Salzwasser-Pool ist einfacher, als Sie vielleicht denken. Hier sind die grundlegenden Schritte, die unser Team bei HSM Exclusive für Sie durchführen kann:
- Analyse des aktuellen Zustands: Zunächst prüfen wir den aktuellen Zustand Ihres Pools und der Ausrüstung, um sicherzustellen, dass alles für die Umstellung bereit ist.
- Installation des Salzwassersystems: Wir installieren ein Salzwasserelektrolysesystem, das das Salz in Chlor umwandelt. Dies erfordert in der Regel keine großen baulichen Veränderungen und kann relativ schnell durchgeführt werden.
- Salzzugabe: Wir fügen die richtige Menge Salz zu Ihrem Pool hinzu. Die Menge variiert je nach Größe des Pools, aber als Richtwert benötigen Sie etwa 3-4 kg Salz pro 1.000 Liter Wasser.
- Kalibrierung und Inbetriebnahme: Nach der Installation und Salzzugabe kalibrieren wir das System und nehmen es in Betrieb. Unser Team stellt sicher, dass alles optimal funktioniert und Ihr Poolwasser perfekt desinfiziert wird.
Fazit
Ein Salzwasser-Pool bietet zahlreiche Vorteile gegenüber einem traditionellen Chlorpool, darunter eine angenehmere Wasserqualität, weniger Wartung und geringere Kosten sowie Umweltfreundlichkeit. Die Umstellung ist unkompliziert und kann von den Experten von HSM Exclusive schnell und effizient durchgeführt werden.
Wenn Sie Interesse an einer Umstellung auf einen Salzwasser-Pool haben oder mehr über unsere Pool Services auf Mallorca erfahren möchten, zögern Sie nicht, uns zu kontaktieren. Wir freuen uns darauf, Ihnen zu einem gesünderen, umweltfreundlicheren und pflegeleichteren Pool zu verhelfen! Lassen Sie sich ein unverbindliches Angebot erstellen, Ihre Anfrage unter + 34 971 69 5353 oder per eMail an info@hsmexclusive.com.